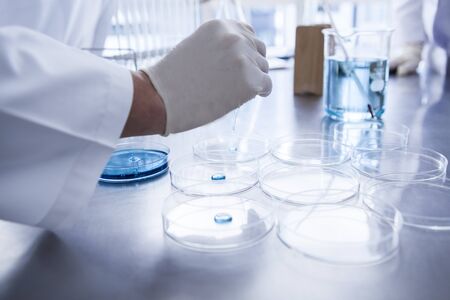
Scientist with Petri dish in laboratory.の写真素材

写真素材 - Scientist with Petri dish in laboratory.
キーワード
- adult
- analyzing
- asia
- beaker
- biochemistry
- biology
- biotechnology
- blue
- building
- chemical
- chemist
- chemistry
- class
- coat
- cool
- dropper
- equipment
- experiment
- expertise
- flask
- future
- glasses
- glassware
- gloves
- goggles
- hair
- hand
- health
- innovation
- intelligence
- japan
- japanese
- lab
- laboratory
- lights
- liquid
- mask
- medical
- medicine
- microbiology
- object
- paper
- people
- pharmaceutical
- pores
- profession
- professional
- research
- researcher
- school
- science
- scientific
- scientist
- shine
- solution
- stripes
- students
- table
- technology
- test
- test tube
- test tube rack
- tube
- white
- white coat
- windows
- woman
- young
類似作品
Scientist pipet...
Petri dishes wi...
Lab bench with ...
a scientist is ...
This image show...
Bacteria and mi...
Team Asian scie...
Technicians in ...
Bacteria or mic...
A scientist in ...
A group of scie...
3D rendering of...
The photo depic...
This stock phot...
Female scientis...
A serene labora...
A clear glass d...
3D rendering of...
A focused resea...
A microbiologis...
high-tech labor...
Food safety ins...
Petri dishes fi...
Science laborat...
A high-tech lab...
A researcher in...
a scientist wor...
Unknown doctor ...
Exploring vibra...
A scientist in ...
Medical discove...
Chemical Labora...
Close-up of che...
Data scientists...
A macro shot of...
Quality control...
young scientist...
Scientific biol...
3d rendering of...
A man in a whit...
Data scientists...
Nurse carefully...
Engineer observ...
Scientist worki...
Modern Laborato...
GMO concept. Sc...
A striking imag...
Scientists work...
GMO concept. Sc...